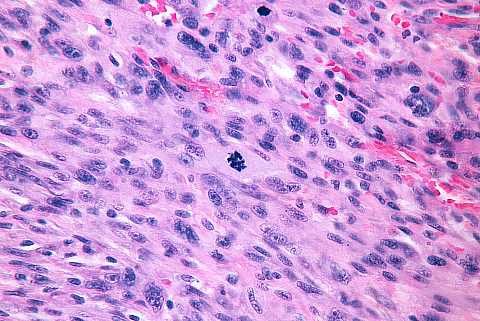
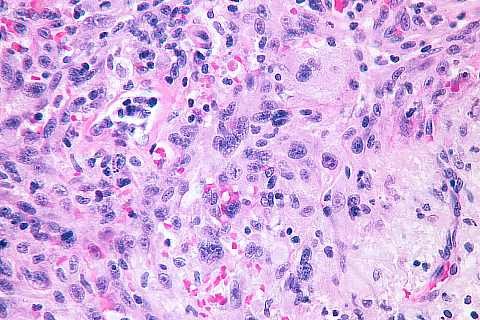

Presenter: Rick Lin DO MPH, Dan J Ladd DO
Dermatology Program: Kirksville College of Osteopathic Medicine Dermatology Department
Program Director: Bill V. Way, DO
Submitted on: Dec 29, 2003
CHIEF COMPLAINT: A spot on the right forehead
CLINICAL HISTORY: Patient with a history of basal cell carcinoma returned to clinic for a follow-up visit to be monitored for possible recurrence of Skin Cancer and to evaluate skin for the possible development of new precancers. The patient was found to have a spot on his right forehead. He did not know how long the spot had been there. The lesion is asymptomatic.
PHYSICAL EXAM:
Red, juicy, dome-shaped nodule that is ulcerated and telangiectatic. The size is 4mm, located on the right forehead. No cervical lymphadenopathy.

LABORATORY TESTS: N/A
DERMATOHISTOPATHOLOGY:
A shave biopsy was performed. Hyperkeratosis and parakeratosis with a proliferation of neoplastic squamous epithelial cells in an irregular pattern with little tendency towards keratinization, and with surrounding fibrosis and inflammatory reaction. Immunoperoxidase stains were positive for CD68, a marker of fibrohistiocytic differentiation, and negative for cytokeratin, S-100 protein, and HMB45 antigen.
High power view in the vicinity of the black line. The characteristic of the pushing border should be assessed on the scan power image since infiltration is seen in the high power view:

High power view near the surface. Cytologically malignant spindle and epithelioid cells are present:
High power view within the main mass of the tumor:
*Slides and description taken from http://www.bweems.com/ with permission
DIFFERENTIAL DIAGNOSIS:
1. Spindle cell squamous cell carcinoma
2. The superficial portion of a malignant fibrous histiocytoma
3. Atypical fibroxanthoma
4. Desmoplastic malignant melanoma
5. Leiomyosarcoma